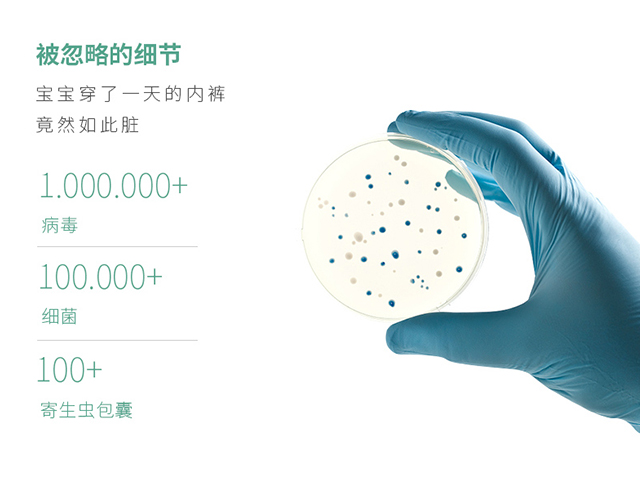
给孩子买什么运动玩具,给孩子买很贵的玩具

我有位闺蜜,不久前发现5岁的儿子特别爱把手伸进*裤内**,摸摸前面,抠抠后面,有时还会把手拿出来闻闻。
本就有洁癖的她大惊失色,认定自己对儿子的性教育有问题,紧急去做各种咨询。
正当她准备用了解到的知识对儿子好好进行一番“教育”时,儿子哭着告诉她:屁股好痒,妈妈挠挠。
她这才注意到,儿子*裤内**太紧,出汗又多,*处私**周围起了不少红疹子。
他妈妈心疼得不行,赶紧带他去医院看了。
医生对她说,“现在很多家长都是这样,给孩子买玩具花多少钱都舍得,但却不注意挑选一条合适的好的*裤内**,孩子很容易因为*裤内**上细菌滋生,而进一步导致炎症啊。”
后来,我才知道,有很多家长都会忽视孩子的生理卫生,总觉得小孩子嘛,怎么会得炎症等“妇科病”呢?
其实,孩子从出生开始就具备完整的生殖系统,虽然发育并不完全,却一样害怕外界细菌的侵扰。而*裤内**,又是特别容易积累细菌的地方,温暖潮湿,还积累了很多分泌物。
世界各国微生物学家研究表明,一条脏*裤内**平均带有0.1克粪便,排泄物中有沙门氏菌、大肠杆菌等病菌,即使正确清洗、晾晒,上面的细菌也难以完全被杀死。
相比国人在儿童生理卫生意识的缺失,法国则对此谨慎得多。
法国是一个对婴幼儿产品安全标准极度重视的国家,例如法国的Mum Chant品牌,安全性远高出国内标准,质量和安全性要求极高,它不仅可以实现“24小时全天抗菌”,让爸爸妈妈们不必再担心*裤内**上的细菌感染问题,还因其舒适性让很多不喜欢穿*裤内**的孩子真正爱上穿*裤内**!

给孩子一条好*裤内**,是给孩子生理教育的最基本的开始
Mum Chant儿童*裤内**有什么特别之处呢?
独家专利技术,24小时全天抗菌
作为一款抗菌*裤内**,最基本的功能就是抗菌。Mum Chant 经过数千次实验检测,真实抗菌效果报告数据显示其抗菌活性高达99%,可实现24小时以上的长效抗菌防护。另外,在体验的孩子中,原本因*裤内**上的细菌感染而造成的*处私**瘙痒,异味、泌尿系统感染等问题都得到了明显好转!

挑选这款儿童*裤内**还有一个重要原因:它是纳米级白铜纤维混纺,相比市面上常见的银离子抗菌技术还要更加有效和持久。

专为儿童设计,舒适呵护娇嫩肌肤
家长们为孩子的挑选*裤内**操碎了心,孩子呢,他们只在乎*裤内**穿着舒不舒服,不然就直接嚷着不要穿*裤内**。
为了给孩子娇嫩的肌肤提供极致舒适的穿着体验,Mum Chant选择了奥地利榉木制成的兰精莫代尔与铜纤维混纺,制成的*裤内**比棉质纤维更薄,吸湿、透气性能超强,再闷热的天气也能时刻保持*处私**干爽。而且具有大于普通*裤内**的3倍超强弹力,贴身不束缚,让孩子运动起来更加自由舒适。


除此之外,Mum Chant在细节处也是精益求精。无痕粘合工艺,手工细密锁边,满足一条*裤内**最极致的“0触感”!

更有荷兰皇室*用御**设计大师设计的礼盒包装,独具收藏价值。从内到外都是极致匠心!


兼具颜值跟品质的Mum Chant儿童*裤内**,全天抗菌,材质舒适,耐穿耐洗。
一款好的*裤内**,可以帮助孩子培养健康的生理意识,是父母在这个阶段给孩子最棒的礼物了吧。